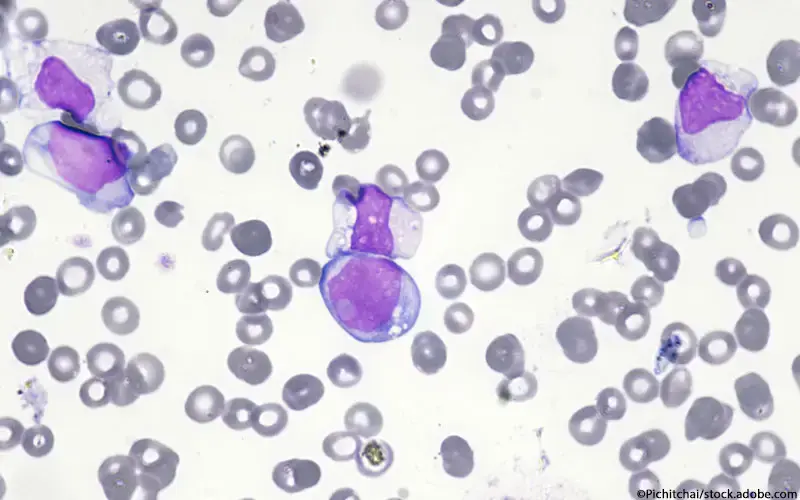
Akute Myeloische Leukämie

Seltene Erkrankungen (Orphan Diseases)
Informationen zu seltenen Erkrankungen (Orphan Diseases) mit Begriffserläuterungen, Kompetenzzentren für seltene Krankheiten, gesetzlichen Bestimmungen und einem Verzeichnis von zugelassenen Orphan Drugs.
Informationen zu seltenen Erkrankungen
Nachrichten zu seltenen Erkrankungen
Anzeige